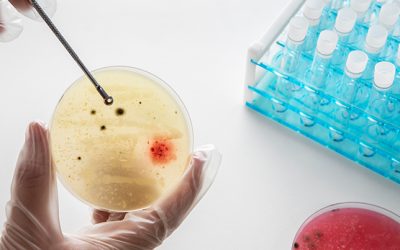
Determining Sanitation Effectiveness with a Robust Environmental Monitoring Program – Part 3

Get latest news,
blogs & posts.
Interested In receiving more articles?
Fill your details in the form below to get more articles.
Can 5S Be a Useful Methodology for the Sanitation Team?
There are multiple benefits to implementation of 5S methodology in the sanitation process and areas, including engagement of the sanitation team The 5S methodology can be implemented for continuous improvement in the food plant sanitation process. First, it will be...
Essentials of Bird Management for Food Processors
Birds: A Flying, Nesting Risk for Your Facility From human health risks to building and equipment damage, birds can be some of the most difficultpests to control for the food processing industry. Knowing your options and even knowing the tips andtricks to help make...
The Importance of a Positive Release Program
Imagine, if you will, this hypothetical scenario: A quality assurance director is sitting in the office when one of the staff comes in.The staffer says, "Boss, we got the results back from lot XYZ, and they are not good."The boss says, "Okay, let's put it on...
Rapid Testing Methods—Processor Preferences
Which rapid microbiological test methods are preferred byfood processors, and what attributes of rapid tests are mostimportant to them? There has been substantial growth in the development and use of rapid methods since theirintroduction to the market over the past 25...
Are Rapid Testing Method Still a Necessary Part of Food Safety?
Due to the well-known risks of working with pathogens in an in-house food laboratory, therehas been a dramatic shift to outsourcing for pathogen samples There has been much discussion in recent years about the use of rapid microbiologicalmethods in food safety testing...
Determining Sanitation Effectiveness with a Robust Environmental Monitoring Program – Part 3
Quantity of Samples The number of samples can be tricky and must be based on a risk assessment. One of the keyfactors is facility size. Industry recommendations include 30–60 sampling sites per 50,000square feet. Another consideration is the product risk. If a...
Determining Sanitation Effectiveness with a Robust Environmental Monitoring Program – Part 2
Timing PEM can serve two purposes for sanitation: For sanitation verification. Did you start out clean? Did the sanitation practices,policies, and procedures achieve the desired cleanliness standard? Test during post rinse or pre-operational inspections. When the...
Determining Sanitation Effectiveness with a Robust Environmental Monitoring Program – Part 1
A PEM program should test for a mix of indicator organisms and a mix of pathogens based onproduct susceptibility and risk. A sanitation program is a key component of any food processor's or food handler's food safetyplan. A well-written and well-executed sanitation...
KLM HIGH-giene Solutions Article and Blog Posts
Look out for exciting industry related articles coming on this page soon!
Send us a message
Contact me
Office Telephone
Mobile
+27 68 384 9194
Enquiries : info@klmhigh.co.za
Accounts : accounts@klmhigh.co.za
Support : Info@klmhigh.co.za
Address
Unit T05, Regus Southdowns Ridge Office Park, John Voster Drive, Irene, Centurion, 0062